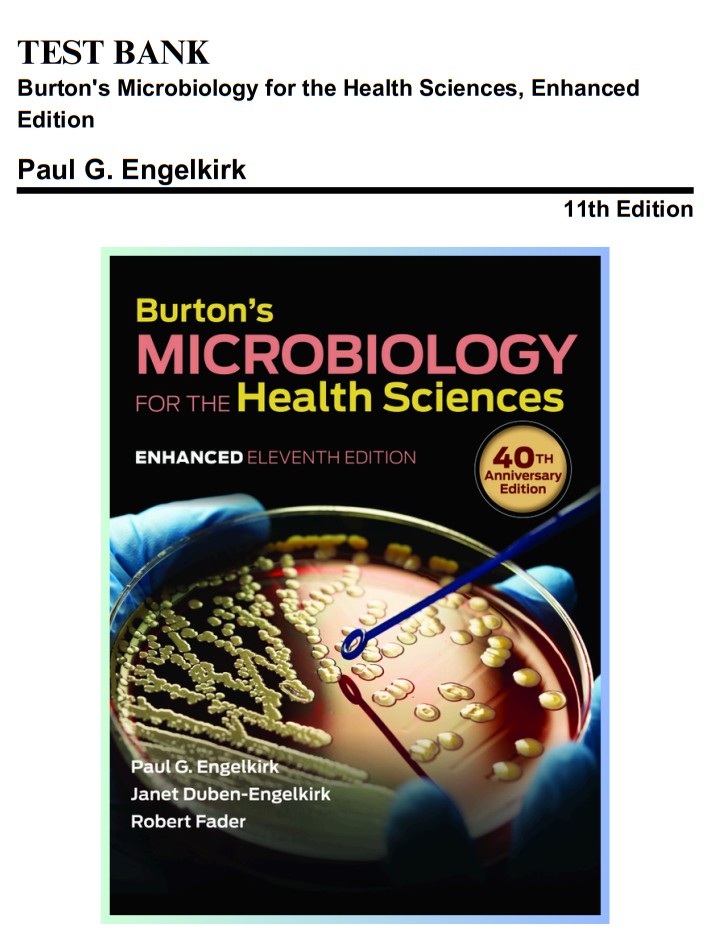
Document Page 1

✨ What You Will Get ✨
Comprehensive Question Bank
Practice with a wide range of exam-style questions designed to match the real test format.
Wide Selection for All Learners
Whether you're reviewing core subjects or preparing for specific exams, our collection offers something for every level.
Organized Layout
Study efficiently with questions grouped by topic and difficulty for structured learning.
Why Choose Us
Save Time
Focus on what matters most with well-organized practice questions and solutions.
Confidence Boost
Prepare with real-style questions to reduce stress and walk into your exam ready.
Clear Solutions
Every question includes a detailed explanation so you understand the reasoning.
Study Anywhere
Access your study material from any device, anytime, anywhere.
Instant Access
Get your resource immediately after purchase with secure, easy download.
Smarter Prep
Focus on key exam concepts designed to maximize your score.
Got Questions? We’ve Got You Covered!
How Soon Can I Access My Test Bank?
You will have immediate access to your test bank as soon as your payment is processed. Once the transaction is complete, you can instantly download your materials in PDF format.
No delays, no waiting—get started on your test preparation right away! 🚀
Are all chapters included, and are there questions for each chapter?
Yes, our comprehensive package includes test questions for every chapter, providing you with a thorough study resource.
Are These Materials Reliable and Accurate?
Absolutely! Our test bank materials are carefully curated and reviewed by experienced professionals to ensure the highest level of accuracy and reliability. Every question comes with 100% verified answers, so you can trust the content to support your learning and exam preparation.
Our commitment to quality ensures that you receive resources that meet the latest academic and testing standards.
Prepare with confidence—our materials are designed to help you succeed!
Are answers to the questions verified?
Yes, all answers provided in the Test Bank are thoroughly verified to ensure accuracy.
Can I Use These Documents on My Phone or Tablet?
Absolutely! The Test Bank is in PDF format, making it compatible with all devices and browsers for your convenience.Whether you’re at home, on the go, or in a study session, our materials are designed for convenience and portability. 📱💻
Why Our Materials Are the Best Choice?
- Comprehensive Coverage – Our materials cover every chapter and topic, ensuring no gaps in your preparation.
- 100% Verified Accuracy – Every question and answer is verified by experts, giving you confidence in your study resources.
- Instant Accessibility – Download your materials instantly and start preparing right away.
- Device Compatibility – Use our materials on any device, including smartphones, tablets, and computers.
- User-Friendly Format – Organized and easy-to-navigate PDFs make studying efficient and straightforward.
- Affordable Excellence – Get high-quality resources at prices that fit your budget.
- Regular Updates – We ensure our materials are always up-to-date with the latest curriculum and exam standards.
Choose our materials and set yourself up for success with the most reliable, accurate, and accessible resources available! 🌟
Feel free to contact us if you have any other questions. We are here to help